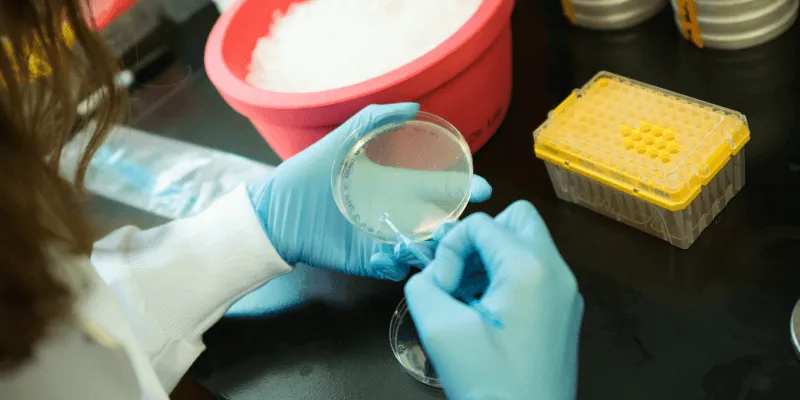

Searching for solutions, focusing on details, and collaborating with a team to improve a process — for graduate student Lorrie Blais, these are the best parts of her job as a technician in the Vermont Department of Health laboratory. They are also what she loves most about her courses at UVM.
While she pursues a master of science in medical laboratory science, Blais works in the health department’s Food Microbiology Laboratory, supporting scientists who test food and environmental samples for harmful bacteria known to cause foodborne illnesses. Due to the COVID-19 pandemic, all non-essential testing at the Vermont Department of Health Laboratory was suspended, and Blais now focuses on COVID-19 detection. She processes high priority COVID-19 specimens, labeling and preparing them for analysis by microbiologists. Blais thrives on the hands-on science and fast-paced problem-solving.
“My brain is naturally wired to constantly think of how I can make something more streamlined, accurate, traceable, and accessible,” Blais says. “Every work day provides different challenges and opportunities for continuous personal and technical growth. There is a nice balance of both independent and collaborative work too, which fits my introverted personality well.”
Medical laboratory science requires technical expertise and professional judgement in collaboration with nurses, physicians, respiratory therapists, microbiologists, pharmacists, radiologic technicians and other health care providers. Blais enjoys the balance of independent and collaborative teamwork and appreciates the chance to apply classroom concepts and practice skills.
“Having the opportunity to already start working in the field I plan to build a career in while also taking classes allows me to integrate what I learn with what I am actually doing in the lab. I’m a lot more comfortable with handling clinical patient specimens.”
What excites her most about her chosen career?
“Nothing is more gratifying to me than doing behind-the-scenes work — tasks that are essential to keep a system running smoothly but are not typically at the forefront of people’s minds,” Blais says. “Behind every courageous health care worker are a number of medical laboratory scientists and public health workers dedicated to providing the critical test results. I can’t think of anything that I don’t love about it!”